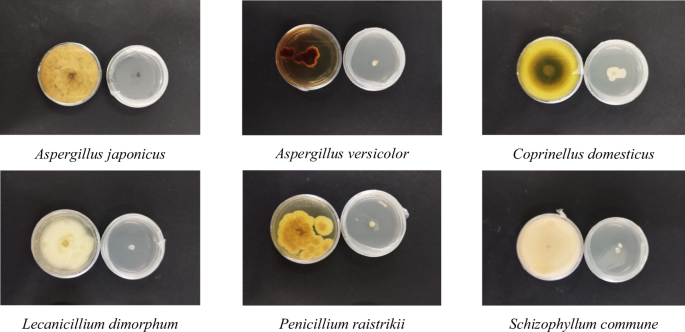
figure 3
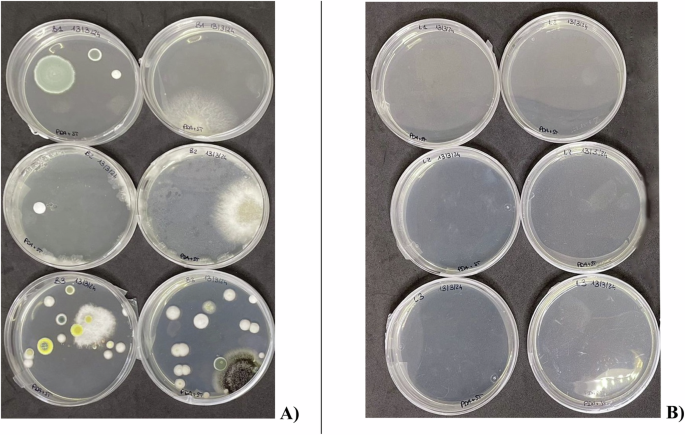
figure 6

Abstract
The present work consists of an applied study on the use of lavender essential oil for the biocidal treatment of a contemporary art manufact conserved and exhibited at the Plart Museum of Plastic Arts and Design in Naples (Italy). The study consists in the proceeding of the previous in vitro trial on fungal species isolated from a contemporary artifact, in which the sensitivity of the microbial consortium to fumigation treatment by exposure to the vapor phase of the essential oil was demonstrated. The aim of this work is to compare the effectiveness of the intervention on the case study by evaluating the long-term antifungal performance of the essential oil and a commercial standard biocide based on benzalkonium chloride. The organic components of the artwork were chemically characterized using Raman and Fourier Transform Infrared Spectroscopy to assess the potential biodegradability of the different materials composing the object. Microbiological monitoring was conducted post-treatment after 1–5 months (using a bioluminometer) and after 4–8 months through new isolation. The results demonstrate that not only is the biocidal effectiveness of the fumigation treatment comparable to that of the commercial product, but it also surpasses it in terms of inhibition percentage and long-term durability.
Similar content being viewed by others
Introduction
Biocidal treatments on cultural heritage represent a standard practice in the art conservation field. These interventions are carried out with a dual purpose. The first is to protect the work of art from damage caused by bio-deteriorating agents, which can seriously compromise its structural and aesthetic integrity. The second purpose is to guarantee the safety of those who interact with the object by disinfecting it from microorganisms that can also be pathogenic for humans1. Bio-based and environmentally friendly biocide products are attracting increasing interest to replace the currently available commercial options, whose eco-toxicological and safety profiles are of concern to the scientific community. Among the most explored alternatives, there is the use of natural extracts, including essential oils 2.
Previous studies have used essential oils for biocidal treatment on various types of artworks2,3. Lavender essential oil has been repeatedly applied by direct contact4 on wooden supports, although it did not always show the best antifungal performance compared to other essential oils5,6. In vitro studies have yielded similar results when compared with rosemary and thyme oils, which demonstrated performance comparable to benzalkonium chloride used as standard7, whereas where lavender essential oil had the highest minimum inhibitory concentration (MIC) for the fungi tested. Lavender oil has also been used to reduce microbial load in museum spaces8 by diffusing it into the environment. However, the literature highlights two critical issues: the first is the species-specific nature of lavender oil, where microbial sensitivity varies from species to species9. The second is the lack of data on the long-term efficacy of essential oil-based treatments.
The present study builds on previous in vitro experiments, which investigated the use of lavender essential oil as a non-contact antifungal treatment for artworks affected by microbial degradation. The in vitro study10 had allowed to highlight that, even starting from the same plant matrix, the application of extraction techniques produced extracts with dissimilar antifungal properties. The study had also suggested that changes in the application methods of the essential oil optimized its antimicrobial efficacy, reducing the oil quantity for treatment. The essential oil extracted by supercritical CO2 showed excellent antifungal properties, when compared to organic solvents-obtained non-polar extracts, with biocidal action both through direct contact and fumigation. In the latter case, the bioactive quantities (IC50) were even lower. The plate study was conducted on a fungal consortium isolated from the wooden support of the contemporary artwork “un-color becomes alter ego #2” (1984) by Haim Steinbach. The contactless application method offers a beneficial option for the preservation of cultural heritage, as it allows to minimize the impact of new substances on the artistic substrate, thus adhering to the principle of minimal intervention. To verify whether the experimental hypothesis tested in vitro could also be confirmed in vivo, a biocidal intervention was designed for the artwork under study, imitating the conditions of the micro-atmosphere treatment of the plates. However, to increase the reproducibility of the experiment, thus limiting the extraction technique and plant matrix variables, and the accessibility of the oil in a typical conservation laboratory, a commercial lavender essential oil was used in the in vivo study. The main bioactive components of commercial lavender essential oils may have quantitative differences, but must comply with the European Pharmacopoeia guidelines. Therefore, it appeared necessary to carry out the case study experiment using a specific standardized product. The main purpose of this experiment was to evaluate the feasibility of the in vitro protocol developed in the previous work and to observe its in vivo performance over time. The final goal is to demonstrate that lavender essential oil used to fumigate an artwork colonized by pathogenic fungal species can indeed act as an alternative intervention to commercial reference products.
Materials and methods
Experimental design: a comparative assessment of traditional and innovative biocidal treatments
The effectiveness of the biocidal treatment using two different products was evaluated through a disinfestation intervention on a contemporary art piece, assessing their antifungal efficacy over time. The aim of the experiment was to explore the possibility of using lavender essential oil for fumigation without direct contact with the artwork and to compare its performance with a reference standard. The case study artwork is “un-color becomes alter ego #2” by Haim Steinbach, created in 1984, which is part of the permanent collection of the Plart Foundation in Naples, Italy11. The object showed fungal colonization on the wooden surface of the plywood, which appeared as a white, powdery mycelium primarily located within the shelving. This was the focus of the experiment. The artwork was treated partly with a commercial reference product and partly with lavender essential oil. The application methods for the products differed: the standard product was applied directly with a brush onto the surface following the standard intervention practices, while for the lavender essential oil, a micro-atmosphere was recreated. Unlike the in vitro study, which observed a shorter period, the effects of the two treatments were monitored for up to 8 months.
The Artwork: characterization of constitute materials
“Un-color becomes alter ego #2” is a complex, multi-material object consisting of a plywood shelving unit, with two of the three sides of the base covered in polychrome laminate. On it are displayed two silicone Yoda masks and a cassette player (Fig. 1, Recto). Looking at the back of the work (Fig. 1, Verso), two rectangular cavities are visible, designed for wall mounting. Inside the shelving unit, there is a plywood panel that divides the work into two sections. The artwork was characterized using three integrated approaches: first, through macroscopic and microscopic observation of the constituent elements; second, through bibliographic research in exhibition catalogs and technical documentation relating to the companies involved by the artist in the creation of the composition; and finally, through spectroscopic techniques to characterize the adhesives, masks, and colors used.
The aim of the investigation, in addition to identifying the materials used by the artist, was to evaluate the potential biodegradability of the various supports by the microbial consortium isolated from the artwork. For macroscopic morphological observation of the masks, a DinoLite AM411-FVW digital microscope (Leica Microsystems, Wetzlar, Germany) was used in both visible (Vis) and ultraviolet (UV) light modes. To conduct microinvasive analyses, fragments of the artwork were collected from each element during the restoration phase. For chemical characterization, attenuated total reflection Fourier transform infrared (ATR FT-IR) spectroscopy was performed using the Nicolet Summit Pro instrument (Thermo Scientific, Waltham, MA, USA).
Sampled fragments from the artwork were contacted with the instrument diamond. Spectra were acquired in the range of 400–4000 cm−1, with a total of 32 scans. By comparing the results with reference spectra in the compound library (Thermo Fisher Scientific OMNIC Software), the main components of each sample were identified based on the percentage of match. The laminate was characterized by Raman spectroscopy with a PerkinElmer RamanFlex 400 equipped with a flexible fiber optic probe. Measurements were performed using an excitation wavelength of 785 nm with 0–150 mW laser power.
In vitro antifungal assay
Fungal species had already been isolated from the wooden surface of the artwork, and six fungal species were identified through molecular techniques and morphological observation: Aspergillus japonicus, Aspergillus versicolor, Penicillium raistrikii, Coprinellus domesticus, Schizophyllum commune, and Lecanicillium dimorphum. These fungi had already shown sensitivity to lavender essential oil. However, to determine the appropriate concentration of commercial oil for biocidal treatment, antifungal tests were repeated by fumigation in 60 mm Petri dishes using PDA culture medium with pure commercial lavender oil (La Saponaria®) following the methods previously reported10. The concentrations tested were 0.05% (0.048% v/v was the concentration required for total growth inhibition by fumigation using supercritical fluid-extracted lavender oil), 0.1% and 0.25% v/v (percentage of total Petri dish volume). The three concentrations were applied on the lid of the reversed Petri plates and the tests were performed in triplicate. The plates were stored at 23 °C in the dark and monitored up to 7 days.
Biocidal treatments
The artwork was virtually divided into two parts, as shown in Fig. 1, to compare the two treatments. The inside of the shelving unit is separated by a panel, so the two internal surfaces are completely separated. Once the appropriate concentration for complete inhibition of fungal growth was determined, it was selected for in vivo application. On the back of the artwork, the left internal surface was treated with a standard benzalkonium chloride-based biocide (Biotin T®, C.T.S. Italia), diluted to 3% in water in a total volume of 200 mL and applied with a brush until completely absorbed (about 12.5 μL/cm2) as prescribed by the technical data sheet (Area B). On the right, pure commercial lavender essential oil was diffused using a common ultrasonic room diffuser (TENEVEAMO®) to facilitate oil evaporation (Area O). The choice to use commercial essential oil instead of oil extracted by supercritical CO2 was driven by the desire to verify the accessibility of the treatment using a product that is easily available and low-cost, ensuring good reproducibility of the treatment in a typical restoration laboratory The artwork was placed inside a heat-sealed PA-EVOH polyethylene barrier (C.T.S., Italy) for 1 month to allow for surface fumigation.
The amount of essential oil placed in the diffuser corresponded to 0.1% v/v of the volume to be treated. Considering the total volume of the artwork, which is ~265,000 cm³ (81 × 164 × 40 cm), the volume to be treated by fumigation was calculated to be approximately half of the total volume (132,000 cm³). Therefore, 132 mL of pure essential oil was introduced into Area O of the shelving unit (~8.25 μL/cm2). After 1 month, the enclosure was opened, and two post-treatment assessments were carried out using a bioluminometer after 1 and 5 months on the treated surfaces (Area B and Area O). In addition, two microbiological samplings were performed from both areas 4 and 8 months after treatment. Finally, the in vivo experiment was conducted within the restoration laboratory of the Plart Foundation Museum in Naples, where the environmental conditions are monitored using a Mini TH Data Logger, and no conditioning system is present.
Post-treatment biological monitoring: bioluminometric assay
At 1 and 5 months after treatment the two surfaces, Area B and Area O, underwent bio-luminometric analysis to detect the presence of Adenosine Triphosphate (ATP) and Adenosine Monophosphate (AMP), and consequently, the ongoing metabolic activity on the treated surfaces. Pre- and post-treatment measurements were carried out using a Lumitester™ PD-30, with LuciPac™ Pen surface swabs used for sampling. Two detection points were chosen for each area, and each measurement was repeated four times. The result is expressed as RLU (Relative Light Units), which indicates the luminescence produced by the sample. The pre-treatment results were compared with those obtained after the biocidal treatment, and based on the numerical values obtained, the percentage reduction in ATP and AMP concentrations in the samples was calculated.
Post-treatment sampling: fungi isolation and molecular identification
After treatment, two samplings were performed on the treated surfaces to assess the potential presence of active fungi and spores. Six sterile oropharyngeal swabs were used, each covering an area of approximately 5 cm × 5 cm on both Areas B and O. The swabs were immersed in a 0.9% NaCl saline solution, and the solution was then inoculated with a sterile spatula onto a 60 mm Petri dish with PDA culture medium (Condalab). The plates were incubated in the dark at 23 °C for 10 days. Isolations were performed 4 and 8 months after treatment. DNA was then extracted using the CTAB protocol with primers ITS1, ITS2, ITS3, and ITS4. The amplification was performed by PCR (Polymerase Chain Reaction) as previously reported10. The DNA samples were quantified using the UV-Vis Thermo Scientific™ NanoDrop™ One, and then sequenced by BMR Genomics in Padua. The identified sequences were uploaded to Chromas Lite software for data cleaning and then compared with the BLAST Nucleotide platform dataset to identify fungal species based on a similarity percentage (>99%). The sequences of the identified fungi have been deposited in GenBank NCBI, and the accession numbers are provided.
Chemical characterization of lavender essential oils: GC-MS and FTIR
The commercial essential oil was analyzed following the method previously described10 to enable comparison between the two essential oils. It was diluted in n-hexane (1:30), and 1 μL was injected into a GC–MS QP2010 instrument (Shimadzu Corp., Kyoto, Japan), consisting of a GC-2010 Plus gas chromatograph coupled with a 2010 Plus single quadrupole mass spectrometer. A 30 m column (JB DB-WAX, 0.25 mm ID, 0.25 μm film thickness, Agilent Technologies, Santa Clara, CA, USA) was used for compound separation, with helium as the carrier gas. The initial temperature of 38 °C was maintained for 1 min, then increased to 120 °C at a rate of 2 °C/min. The gas flow was set at a constant linear velocity of 45 cm/s, and the split ratio was 12:1. The mass spectrometer had a solvent cut time of 2.5 min. Before conducting the analysis, a solvent blank was run, and each sample was analyzed in triplicate. Peak areas were normalized based on the detected signal strength, and compound identification was performed by comparing each peak mass spectrum with the NIST library collection (NIST, Gaithersburg, MD, USA), considering matches percentages >89%. This untargeted analysis, conducted without a standard reference, provided a relative and semi-quantitative composition of the essential oil. ATR-FTIR analyses were carried out by Shimadzu IRXross Fourier Transform Infrared Spectrometer with single-reflection ATR accessory using a diamond crystal (QATR10). FTIR-ATR spectra were processed with Lab solution IR software (v.1.60, Shimadzu, Tokyo, Japan).
Results and discussion
The artwork: characterization of constitute materials
Plywood
The plywood support was manufactured by the American company Roseburg, which specializes in the production and assembly of wooden panels. The stamp “Roseburg Resin Tite® Hot Pressed Exterior Glue” helped trace the brand “Resin Tite,” established in 1958, which includes a series of resin-based adhesives used in industrial applications and produced by Roseburg (Fig. 2A). This type of plywood is produced by Roseburg under the name “Marine – Sanded Plywood” and features six alternating grain layers (Fig. 2B), creating a support that is physically and mechanically resistant to thermo-hygrometric fluctuations, effectively eliminating the anisotropy of the individual wood layers. Based on the technical data sheets of the laminated support provided by Roseburg (“Particleboard, laminated or coated” Safety Data Sheet, Section 3, Composition/Information on Ingredients), the product composition includes wood dust (soft/hard wood, from 80 to 100%), urea polymer with formaldehyde and 1,3,5-triazine-2,4,6-triamine (CAS-No.: 25036-13-9; 7–30%), and melamine (CAS-No.: 108-78-1; 1–5%). Confirming this information, studies on chemical characterization conducted through Raman spectroscopy on laminates used for furniture and design objects produced between the late 1930s and the late 1980s12 have shown that most samples featured a core of lignin and cellulose, a resin layer based on melamine formaldehyde, and urea formaldehyde as an impregnating adhesive. The literature indicates that in the early twentieth century, various thermosets, including phenol formaldehyde (PF) and urea formaldehyde (UF), were used as binding mediums, with melamine formaldehyde (MF) being the latest addition over time. As time progressed, variations in composition became less common13. The findings of this study suggest a relatively consistent use of materials, with MF, cellulose-based material containing lignin (kraft paper), and pure cellulose being the most frequently used.
Laminate
The results obtained by the Raman investigation were not entirely resolutive on the pigment used for the laminate (Table 1). For the green area, the main peaks show correspondence with the spectrum of cadmium green pigment, as emerged from the comparison with the open access pigments library “Cultural Heritage Science”. In fact, the characteristic peaks match at ~1535 cm–1, ~1455 cm–1, 1345 cm–1, 750 cm−1, ~685 cm−1, ~485 cm−1. As for the brown area, only few peaks were detectable at 2595 cm–1, 1450 cm–1, 984 cm–1, and 637 cm−1 but no correspondence has been found. This is possibly due to the fact that synthetic brown is a result of a mixture of different pigments (red+blue+yellow, orange+blue, or yellow+purple) and as a consequence no characteristic peaks can be identified for the color, it most likely consists of the sum of at least two pigments overlaying spectra. Concerning the support composition, it is possible to hypothesize the main components from the cross-section sample: the profile of the spectrum finds some similarities with melamine and melamine-formaldehyde formulations14. Indeed, there is a characteristic double peak at a wavelength of ~2900–3000 cm–1 and another intense peak at ~1000 cm−1. Literature data highlighted that bands intensity may vary based on the M/F ratio and in general on the specific composition (paraformaldehyde, formalin, methylenediurea). In fact, two closely spaced peaks can be identified in the different formulations (with varying intensities) around ~1600 cm–1 and another stronger peak at ~1440 cm–1, as well as two peaks at ~600 cm–1 and ~450 cm−1. This result confirmed literature evidence and that obtained from the laminate manufacturer on the support composition.
Stereo radio recorder
The radio that is part of Steinbach’s work is the FM-AM-FM Stereo Radio Cassette Recorder RX-5085 model produced by Panasonic and sold from 1982 to 1983. It consists of an external plastic casing and an internal operating mechanism with the electrical part. The buttons on the front are plastic covered with a metal alloy foil (generally based on nickel, chrome, zinc, and copper) while the antenna and handle are metal.
Silicone masks
Don Post Studios has a license from 20th Century-Fox to sell masks from the Star Wars film saga (1997 LUCAS FILM LTD). The results of the FTIR-ATR investigation identified some components of the masks (Table 2 and Supplementary Materials). The spectrum related to the support suggests that the mask composition is based on polyacrylate silicone: the low matching percentage with polyacrylate indicated by the library (73%) can be read considering that the peaks from at least three mixed components are present: silicone, polyacrylate, and pigment. The literature indicates that silicon shows highest peaks at: ~1030, ~1090, ~1260, and ~2900 cm−1. These peaks overlap with those pertinent with the presence of polyacrylate as for the broad one at ~3400–3300 cm−1 15. By scraping off the brownish glaze from the silicone, FTIR analysis revealed the use of an alumino-silicate pigment commonly used in acrylic paint formulations. Presumably, while the silicone was mixed with the green color directly during the creation of the mask from the mold, the details of the eyes and the shading of the wrinkles were realized by glazing afterward. The spectrum related to the filler confirms the styro-foam composition and provides information on the type of adhesive used to glue the spheres together and to the inner wall of the mask: it is an acrylic adhesive, more precisely identified as Primal AC 33 medium acrylic adhesive. Six plywood veneer samples were analyzed showing wood fingerprint peaks: the large band at ~3400 cm−1 is related to O–H stretching revealing the presence of alcohols, phenols, and acids; as well as the broad one ~1600–1700 cm−1 corresponds to vibrations due to lignin aromatic moiety, plus C=O stretching; it was tentatively identified as pine wood16. In the synthetic hair sample an identity with the composition of nylon, based on polyamides, was found.
Biodegradability of materials
The laminated plywood support is industrially produced for domestic uses, mainly for furniture manufacturing, which is why the resin coating makes it particularly resistant to wear damage and, naturally, to microbiological degradation. However, the wooden support, despite being made of processed and unprocessed raw materials, and generally assembled with acrylic and/or phenolic resins, can be subject to colonization by white- and brown-rotting fungi that conduct enzymatic activity on lignin and cellulose but are generally able to catabolize other phenolic compounds as well17. Even in processed wooden materials, a deep fungal colonization can be observed, the extent of which depends on environmental conditions (mainly the presence of water and relative humidity)18 and the morphological characteristics of the veneers (composition and type of porosity)19. Studies conducted on laminated plywood supports treated with urea formaldehyde as an impregnating agent have shown that the support becomes more resistant to colonization by white rot fungi, reducing degradation in terms of weight loss by 62% compared to the same untreated material. This result confirms the greater durability of this type of support but evidently does not guarantee complete resistance against microbial agents20.
Another organic material, and consequently potentially affected by microbiological degradation, is silicone. However, no scientific evidence related to the bio-deterioration of silicone by microorganisms have been found, except for a few reported and minor cases21. A different scenario is observed for plastics and celluloid-based materials, which are present in small amounts in the composition of the case study, such as in the case of the stereo buttons. For these materials, there is evidence that they can be colonized by a wide variety of fungi, including white rot fungi, which typically prefer woody and cellulosic substrates22. From these considerations, and from the macroscopic observation of the state of conservation of the work, the substrate that has shown signs of active and widespread fungal colonization is the wooden support. On the contrary, in the cases of laminate, silicone masks, and stereo, no microbiological degradation has been observed, which seems to be less likely, as demonstrated by the cited literature.
Biocidal treatment
Commercial lavender essential oil has showed biocidal activity starting at 0.1% v/v concentration (on the total treated volume) for all fungi that constituted the microbial consortium identified during the first isolation (Fig. 3). The lowest concentration tested (0.05% v/v) did not completely inhibited the fungi growth. As shown in the previous in vitro study10, at low concentrations the antifungal activity appeared to be more species-specific. In fact, Aspergillus japonicus had already shown greater resistance to lavender essential oil, requiring at least 0.048% v/v of the substance in a micro-atmosphere, compared to the other isolates for which concentrations as low as 0.02–0.01% v/v or even lower were sufficient. Increasing the concentrations provides a broader spectrum of activity and a more stable antifungal activity over time. Thus, the lowest concentration tested that ensured complete inhibition of all isolated fungi, corresponding to 0.1% v/v, was selected. The experiment was then replicated in vivo with the artwork using the described concentration (Fig. 4). The experiment, which includes both the treatment duration and monitoring, was carried out under the environmental conditions of the laboratory, which is not provided with any conditioning system. The thermo-hygrometric parameters measured annually indicate that, on average, the temperature (T) is 20.6 °C (Tmin ~ 18 °C; Tmax ~ 23 °C), while the Relative Humidity (RH) is 65.5% (RHmin ~ 51%; RHmax ~ 80%). These environmental conditions exhibit seasonal fluctuations in the minimum and maximum values, as well as variations in RH related to the flow of people present in the spaces. However, the average values comply with the guidelines set by the UNI10829 standard for the conservation parameters of collections of heterogeneous organic materials.
Chemical profiling: commercial and extracted lavender essential oil
From a first observation of the FTIR-ATR spectra of the two analyzed lavender essential oils (Fig. 5), overlapped characteristic peaks were detectable: the broad O–H stretch (~3400 cm−1) which is more visible in the essential oil extracted through Supercritical CO2 (Leo) in Lamiaceae plants is connected to high content on phenolics and flavonoids. The double peak at ~2900 cm−1 is attributable to the C–H stretch; the C=O stretch is detectable at ~1700 cm−1, and C–O stretch (~1100 cm−1) reveals the presence of terpenoid components. The peak at ~1450 cm−1, which is more intense in the Leo sample, is proportional to the number of CH2 and CH3 groups present. The tiny peak visible at ~1640 cm−1 is usually associated to the RHC = CH2 vibration, more precisely with the presence of linalool and linalool acetate. Although same oil samples produce very similar spectral fingerprints, there is a visible difference in terms of intensity of the spectra from the extracted essential oil and the commercial one. In fact, dilution of an essential oil with a non-polar organic solvent not participating in hydrogen bonding may lead to significant differences in terms of the shape and intensity of the respective bands23.
The results on the composition of the main volatile components of the essential oil, obtained by chemical characterization by GC-MS, are summarized in Table 3. Looking at the concentrations of the identified compounds, it is clear that commercial lavender oil has as its main constituents linalyl acetate, linalool, camphor, 1,8-cineole and lavandulyl acetate. Since both analyses were conducted without an internal standard10, the reported relative percentages are meant to be referred only to the sample itself. Therefore, the comparison between the two oils cannot be developed through the percentages but only considering the major components in order of concentration. As already demonstrated in the literature, it is common for linalyl acetate and linalool to be the major components, especially in commercial oils, as these compounds are responsible for the characteristic fragrance24. Regarding these two compounds, the literature highlights good results in terms of antifungal activity, albeit with some differences25,26. In both oils, 1,8-cineole is present in large amounts, and it is a compound known for its good antimicrobial properties27. A clear difference can be observed for terpinen-4-ol, which in the oil extracted in the previous study appears as the major component along with borneol. Both the ATR-FTIR analysis and the GC-MS investigation show that there is a match in the content of the key components, although in different ratio. Therefore, it can be hypothesized that the synergistic activity of the major components found in both oils allowed for good antimicrobial activity, but it is not possible to attribute its antifungal efficacy to a specific bioactive component.
Post-treatment bioluminometric assay
The first bio-luminometric detection 1 month after the treatment revealed the total absence of ATP and AMP from the treated surfaces, indicating that, at the first monitoring, both treatments were equally effective. However, the second detection 5 months after the treatment showed the following results: the area subjected to traditional treatment with commercial biocide (Area B) again reported the presence of ATP and AMP, indicating a beginning of recolonization. However, compared to the pre-treatment data, the percentage content of the two substances corresponds to only 12.78% of the initial concentration, confirming an antibiotic activity of the product with an effectiveness of ~87.22%. As for the areas treated with essential oil fumigation (Area O), the percentage concentration of ATP and AMP is only the 7% of the pre-treatment level, demonstrating a decrease of 92.99% compared to the initial values.
Post-treatment fungi identification
The first isolation carried out 4 months after the treatment did not show any fungal growth in either of the treated areas, Area O and B, confirming the result previously obtained with bio-luminometric analyses, which indicated very low metabolic activity as shown by the ATP and AMP concentration percentages found (approximately 12% for Area B and 7% for Area O). However, after 8 months, the isolation produced a clear differentiation between the two treatments: while no fungal species were found in the culture plates for Area O, five fungi were isolated and identified in Area B (Fig. 6).
The following fungi have been identified: Stereum hirsutum (PP972400-403), Arthrinium marii also known as Apiospora marii (PP972721-23), Aspergillus versicolor (PP972731-34), Aspergillus sp. (PP973133-36), Talaromyces sp. (PP973171-72).
The first of the identified fungi is S. hirsutum, known to be a Basidiomycota wood-decay fungal species, as it is rich in ligninolytic enzymes28,29: these fungi produce a typical degradation called “white rot”. The term refers to the bleached (white) appearance often seen on wood affected by these fungi. A common trait among white rot fungi is their ability to break down all major components of the plant cell wall (cellulose, hemicelluloses, and lignin). The decomposition of lignocelluloses is achieved by a series of enzymatic (hydrolases and oxidoreductases) and non-enzymatic mechanisms and the production of ligninolytic enzymes is typical of this fungi group. In selective delignification, the white rot fungi preferentially remove lignin from wood, causing moderate losses of hemicelluloses and leaving cellulose practically intact or only slightly degraded: this is the reason why the residual substrate has a light color appearance30.
The second fungus belongs to the genus Arthrinium, a pathogenic species that has recently been reported by the scientific community because, although it has already been isolated from soil, plants, and algae, it has now been identified as a dangerous species for certain types of Mediterranean crops31,32. Regarding A. versicolor, it is a fungus previously isolated on the artwork and one of the most found on other wooden artistic supports, as highlighted in other studies33,34. The literature shows that the first two fungi mentioned belong to common species in open environments, mostly isolated from soil, tree species, and cultivated plants, and due to their enzymatic activity, they easily grow on wooden and lignified supports, thus representing a threat to the artistic support in question. As for the species belonging to Aspergillus sp., they are mostly environmental microorganisms whose mechanisms of biodegradation towards artistic artifacts on organic support are not always clear, but they can still perform metabolic functions on the substrate, thus causing pH variations, releasing organic acids and pigmented substances33. Some studies conducted in vivo on wooden artifacts using essential oils fumigation generally show monitoring results only during the treatment and immediately afterward, while there is not much data on the durability of this type of intervention35,36. However, this application aspect is the most crucial, as it truly allows for evaluating the feasibility of this treatment as an alternative intervention to those regularly conducted.
From the results achieved in this study it is evident that the wood, probably due to its porosity, absorbs at least superficially the volatile components to which it is exposed during the 4-week fumigation period. These not only perform a biocidal action during the intervention period but also remain on the surface, ensuring long-lasting antimicrobial protection.
The mixture of benzalkonium chloride, although achieving good antifungal performance in the short term, does not guarantee protection against recolonization over time, which is why the treatment generally needs to be repeated frequently (once a year). It is worth noting that the widespread use of BAC-based mixtures for years has raised numerous concerns from the perspective of eco-pharmacovigilance due to issues of eco-sustainability and safety for those exposed to these substances37. Furthermore, it has been proven that the repeated use of these substances lead to an adaptive response from the target microorganisms, which develop bio-resistance over time38,39,40.
Lavender essential oil has been extensively studied for its antioxidant, anti-inflammatory, antiseptic, and sedative properties, both for topical use and inhalation41,42,43,44,45. Some of its bioactive components have been evaluated for potential cytotoxicity risks to human cells, but it has been shown that only certain pure components used at high concentrations may pose risks to epithelial cells46. However, this is not the case with essential oils, which, as a whole, are composed of hundreds of substances in very low concentrations, regulated by minimum and maximum limits set by pharmacopoeias. Consequently, the use of pure essential oil does not pose a risk to the operator, although personal protective equipment should always be used during all stages of any restoration interventions.
In a previous study7, the antifungal properties of BAC and the essential oil of Lavandula angustifolia by fumigation were compared on a plate similarly to how it was done for this study, but with a very different result: BAC was effective at much lower concentrations compared to those of the essential oil (in the scale of one hundred times lower), concluding that the biocidal activity of BAC has been confirmed while that of lavender essential oil is just sufficient to inhibit fungal growth. It should also be considered that in the cited study, BAC was diluted at 10% (differently from what is recommended for application to cultural heritage items, which foresees a maximum dilution of 3%) and there is no reference to antifungal performance assessment over time. In our study, the effectiveness of both substances in the short term has been proven. Although it is known that antifungal treatments should be carried out as a regular preventive measure to ensure continuous protection of the artifact, this experimentation has shown that the use of lavender essential oil turns out to be more durable over time compared to the reference standard, functioning not only as a biocide but also as an inhibitor against spores and conidia, preventing microorganisms in a pre-germinative state from growing.
Conclusions
The present study concluded the experimental research on the use of lavender essential oil on a contemporary art object subjected to fungal colonization to evaluate the applicability of the treatment previously tested in vitro. In this case study, thanks to the chemical characterization of all the organic components assembled in the artwork, it was possible to highlight that the wooden support is the most exposed to microbiological risk, while the silicone and laminate supports are generally more inert to this type of degradation. From this work, it can be concluded that, when using the same amount of biocide and essential oil, the latter has greater long-term biocidal effectiveness, as it acts not only on the mycelium but also on the conidia, which are microorganisms in a pre-germination state. This aspect confirms what had already been demonstrated in vitro, when in the previous study, lavender essential oil completely inhibited the growth of the conidial suspension. In fact, the total absence of isolates in the fumigated area shows that the fumigant treatment is not only capable of curing an ongoing fungal attack but also preventing its development over time, for at least 8 months after treatment. Therefore, it can be concluded that fumigant lavender essential oil treatment may be a valid, simple, eco-sustainable, and low-cost alternative for biocidal treatment of artistic supports. Further studies, however, could be useful to evaluate other types of supports and potential interactions with the original materials that were not observed in the present study.
Naturally, no antifungal treatment is permanent, and it is always necessary to carry out microbiological monitoring to assess the development of contamination over time, especially if the conservation environment is not directly addressed.
Data availability
No datasets were generated or analysed during the current study.
References
Pinheiro, A. C., Sequeira, S. O. & Macedo, M. F. Fungi in archives, libraries, and museums: a review on paper conservation and human health. Crit. Rev. Microbiol. 45, 686–700 (2019).
Paolino, B., Sorrentino, M. C. & Pacifico, S. Greener solutions for biodeterioration of organic-media cultural heritage: where are we? Herit. Sci. 12, 334 (2024).
Russo, R. & Palla, F. Plant essential oils as biocides in sustainable strategies for the conservation of cultural heritage. Sustainability 15, 8522 (2023).
Wendt, J. et al. Natural sources in preventive conservation of naturally aged textiles. Fibres Text. East. Eur. 29, 80–85 (2021).
Geweely, N. S. et al. Eco-friendly preservation of pharaonic wooden artifacts using natural green products. Appl. Sci. 14, 5023 (2024).
Bahmani, M. & Schmidt, O. Plant essential oils for environment-friendly protection of wood objects against fungi. Maderas: Cienc. Tecnol. 20, 325–332 (2018).
Stupar, M. et al. Antifungal activity of selected essential oils and biocide benzalkonium chloride against the fungi isolated from cultural heritage objects. S. Afr. J. Bot. 93, 118–124 (2014).
Ilieș, D. C. et al. Museal indoor air quality and public health: an integrated approach for exhibits preservation and ensuring human health. Sustainability 14, 2462 (2022).
Geweely, N., Afifi, H., Ibrahim, D. & Mahmoud, M. Efficacy of essential oils on fungi isolated from archaeological objects in Saqqara excavation, Egypt. Geomicrobiol. J. 36, 148–168 (2018).
Paolino, B. et al. Lavandula angustifolia mill. for a suitable non-invasive treatment against fungal colonization on organic-media cultural heritage. Herit. Sci. 12, 53 (2024).
Cecchini, C. & Hansen, A. Polymeric materials in art and design: an Italian interdisciplinary experience. J. Plast. History http://www.dg-kunststoffgeschichte.de/de/e-plastory (2014).
Jacquemain, A. et al. Exploratory investigation of historical decorative laminates by means of vibrational spectroscopic techniques. Herit. Sci. 11, 98 (2023).
Jester, T. C. Twentieth-century Building Materials: History and Conservation (Getty Trust Publisher, 2014).
Scheepers, M. L., Gelan, J. M., Carleer, R. A., Adriaensens, P. J. & Vanderzande, D. J. Investigation of melamine-formaldehyde cure by Fourier transform Raman spectroscopy. Vib. Spectrosc. 6, 55–69 (1993).
Ma, C. et al. Synthesis and characterization of polyacrylate composite and its application in superhydrophobic coating based on silicone-modified Al2O3. Polym. Bull. 79, 5279–5303 (2022).
Esteves, B., Velez Marquez, A., Domingos, I. & Pereira, H. Chemical changes of heat treated pine and eucalypt wood monitored by FTIR. Maderas: Cienc. Tecnol. 15, 245–258 (2013).
Castaño, J. D. et al. Metabolomics highlights different life history strategies of white and brown rot wood-degrading fungi. mSphere 7, 29 (2022).
Van den Bulcke, J., De Windt, I., Defoirdt, N., De Smet, J. & Van Acker, J. Moisture dynamics and fungal susceptibility of plywood. Int. Biodeterior. Biodegrad. 65, 708–716 (2011).
Lewinska, A. M. et al. Visualization of the structural changes in plywood and gypsum board during the growth of Chaetomium globosum and Stachybotrys chartarum. J. Microbiol. Methods 129, 28–38 (2016).
Loh, Y. F. et al. Resistance of phenolic-treated oil palm stem plywood against subterranean termites and white rot decay. Int. Biodeterior. Biodegrad. 65, 14–17 (2011).
Robert J. et al. Assessment of Susceptibility to Biodeterioration of Selected Polymers and Resins (The Getty Conservation Institute, 1988).
Bautista-Zamudio, P. A., Flórez-Restrepo, M. A., López-Legarda, X., Monroy-Giraldo, L. C. & Segura-Sánchez, F. Biodegradation of plastics by white-rot fungi: a review. Sci. Total Environ. 901, 165950 (2023).
Agatonovic-Kustrin, S. et al. Essential oil quality and purity evaluation via FT-IR spectroscopy and pattern recognition techniques. Appl. Sci. 10, 7294 (2020).
Todorova, V., Ivanov, K., Georgieva, Y., Karcheva-Bahchevanska, D. & Ivanova, S. Comparison between the chemical composition of essential oil from commercial products and biocultivated Lavandula angustifolia mill. Int. J. Anal. Chem. 2023, 1–6 (2023).
Caprari, C. et al. Chemical profile, in vitro biological activity and comparison of essential oils from fresh and dried flowers of Lavandula angustifolia L. Molecules 26, 5317 (2021).
Zhang, C. et al. Antifungal natural products and their derivatives: a review of their activity and mechanism of actions. Pharmacol. Res. - Mod. Chin. Med. 7, 100262 (2023).
Morcia, C., Malnati, M. & Terzi, V. In vitro antifungal activity of terpinen-4-ol, eugenol, carvone, 1,8-cineole (eucalyptol) and thymol against mycotoxigenic plant pathogens. Food Addit. Contam. Part A Chem. Anal. Control Expo. Risk Assess. 29, 415–422 (2012).
Zhuo, R. & Fan, F. A comprehensive insight into the application of white rot fungi and their lignocellulolytic enzymes in the removal of organic pollutants. Sci. Total Environ. 778, 146132 (2021).
Peighami Ashnaei, S., Jafary, H. & Afshari Azad, H. The occurrence of Stereum hirsutum associated with wood rotting of olive trees in Iran. J. Hortic. Res. 30, 41–44 (2022).
Peralta, R. M. et al. In Biotechnology of Microbial Enzymes 119–149 (Elsevier, 2017).
Agustí-Brisach, C. et al. First report of Apiospora marii causing wilt and dieback in olive trees in Spain. J. Plant Pathol. 105, 359–359 (2022).
Gerin, D., Nigro, F., Faretra, F. & Pollastro, S. Identification of Arthrinium marii as causal agent of olive tree dieback in Apulia (Southern Italy). Plant Dis. 104, 694–701 (2020).
Romero, S. M., Giudicessi, S. L. & Vitale, R. G. Is the fungus Aspergillus a threat to cultural heritage? J. Cult. Herit. 51, 107–124 (2021).
Sabatini, L., Sisti, M. & Campana, R. Evaluation of fungal community involved in the bioderioration process of wooden artworks and canvases in Montefeltro area (Marche, Italy). Microbiol. Res. 207, 203–210 (2018).
Palla, F., Bruno, M., Mercurio, F., Tantillo, A. & Rotolo, V. Essential oils as natural biocides in conservation of cultural heritage. Molecules 25, 730 (2020).
Sparacello, S. et al. Thymus vulgaris essential oil and hydro-alcoholic solutions to counteract wooden artwork microbial colonization. Appl. Sci. 11, 8704 (2021).
Liao, M., Wei, S., Zhao, J., Wang, J. & Fan, G. Risks of benzalkonium chlorides as emerging contaminants in the environment and possible control strategies from the perspective of ecopharmacovigilance. Ecotoxicol. Environ. Saf. 266, 115613 (2023).
Merchel Piovesan Pereira, B. & Tagkopoulos, I. Benzalkonium chlorides: uses, regulatory status, and microbial resistance. Appl. Environ. Microbiol. 85, e00377–19 (2019).
Kampf, G. Adaptive microbial response to low-level benzalkonium chloride exposure. J. Hospital Infect. 100, e1–e22 (2018).
Kim, M. et al. Widely used benzalkonium chloride disinfectants can promote antibiotic resistance. Appl. Environ. Microbiol. 84, e01201–e01218 (2018).
Samuelson, R., Lobl, M., Higgins, S., Clarey, D. & Wysong, A. The effects of lavender essential oil on wound healing: a review of the current evidence. J. Alternative Complementary Med. 26, 680–690 (2020).
Yoo, O. & Park, S. A. Anxiety-reducing effects of lavender essential oil inhalation: a systematic review. Healthcare 11, 2978 (2023).
Altaei, D. T. Topical lavender oil for the treatment of recurrent aphthous ulceration. Am. J. Dent. 25, 39–43 (2012).
Huang, M. Y., Liao, M. H., Wang, Y. K., Huang, Y. S. & Wen, H. C. Effect of lavender essential oil on LPS-stimulated inflammation. Am. J. Chin. Med. 40, 845–859 (2012).
de Melo Alves Silva, L. C. et al. Use of Lavandula angustifolia essential oil as a complementary therapy in adult health care: a scoping review. Heliyon 9, e15446 (2023).
Prashar, A., Locke, I. C. & Evans, C. S. Cytotoxicity of lavender oil and its major components to human skin cells. Cell Prolif. 37, 221–229 (2004).
Author information
Authors and Affiliations
Contributions
B.P. carried out the experiments and data curation and visualization, conducted the FTIR on the essential oils, drafted the manuscript; M.C.S. performed the isolation and identification of fungal species; A.M. and C.Z. carried out the FTIR analysis on the artwork and bioluminometric assay, S.I. carried out the Raman analysis; J.T. conducted the GC-MS analysis; E.L. supervised the microbiological assays; A.H. and G.R. supervised the restoration treatment, S.P. supervised the work and revised the paper.
Corresponding authors
Ethics declarations
Competing interests
The authors declare no competing interests.
Additional information
Publisher’s note Springer Nature remains neutral with regard to jurisdictional claims in published maps and institutional affiliations.
Supplementary information
Rights and permissions
Open Access This article is licensed under a Creative Commons Attribution-NonCommercial-NoDerivatives 4.0 International License, which permits any non-commercial use, sharing, distribution and reproduction in any medium or format, as long as you give appropriate credit to the original author(s) and the source, provide a link to the Creative Commons licence, and indicate if you modified the licensed material. You do not have permission under this licence to share adapted material derived from this article or parts of it. The images or other third party material in this article are included in the article’s Creative Commons licence, unless indicated otherwise in a credit line to the material. If material is not included in the article’s Creative Commons licence and your intended use is not permitted by statutory regulation or exceeds the permitted use, you will need to obtain permission directly from the copyright holder. To view a copy of this licence, visit http://creativecommons.org/licenses/by-nc-nd/4.0/.
About this article
Cite this article
Paolino, B., Sorrentino, M.C., Macchia, A. et al. Lavender essential oil for a contactless application for contemporary art conservation: a case study. npj Herit. Sci. 13, 8 (2025). https://doi.org/10.1038/s40494-025-01642-w
Received:
Accepted:
Published:
Version of record:
DOI: https://doi.org/10.1038/s40494-025-01642-w